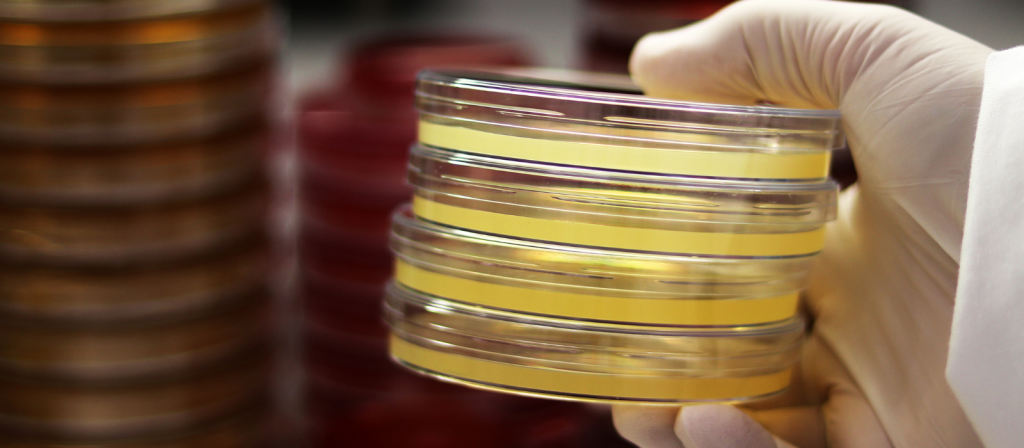

Meios de Cultura Himedia: Agregando Valor ao seu Laboratório
Quando se trata de realizar pesquisas científicas de alta qualidade, a escolha dos meios de cultura adequados é essencial para o sucesso do seu laboratório. A Himedia é uma marca renomada que se destaca como uma escolha confiável para cientistas e pesquisadores em todo o mundo. Neste artigo, vamos explorar como os meios de cultura Himedia podem agregar valor significativo ao seu trabalho laboratorial.
Por que escolher Himedia?
A Himedia é uma empresa que se estabeleceu como líder na produção de meios de cultura microbiológica e reagentes de alta qualidade. Ao escolher produtos Himedia, você está investindo em décadas de experiência e inovação em microbiologia. A marca é conhecida por sua dedicação à qualidade, pureza e consistência de seus produtos, tornando-a a escolha ideal para garantir resultados precisos e confiáveis em suas pesquisas.
Variedade de Meios de Cultura
Uma das maiores vantagens de usar meios de cultura Himedia é a ampla variedade de opções disponíveis. Eles oferecem uma gama abrangente de meios de cultura para diferentes tipos de microrganismos, incluindo bactérias, fungos e células animais. Isso permite que você escolha o meio de cultura perfeito para suas necessidades específicas, garantindo que suas culturas cresçam de maneira ideal.
Consistência e Confiabilidade
Os meios de cultura Himedia são fabricados com os mais altos padrões de qualidade e seguem estritas diretrizes de controle de qualidade. Isso significa que você pode confiar na consistência dos resultados em todas as suas experimentações. A confiabilidade é crucial na pesquisa científica, e os produtos Himedia fornecem essa tranquilidade.
Suporte Técnico
Além de oferecer produtos excepcionais, a Himedia também fornece um excelente suporte técnico. Se você tiver dúvidas sobre como usar um meio de cultura específico ou encontrar problemas durante suas culturas, a equipe de suporte da Himedia estará à disposição para ajudar. Ter acesso a esse nível de assistência técnica pode economizar tempo e evitar frustrações em seu laboratório.
Custo-Benefício
Embora a qualidade dos produtos Himedia seja inegável, eles também são conhecidos por serem uma opção acessível. Isso é particularmente importante em um ambiente de pesquisa, onde os orçamentos podem ser limitados. Ao escolher meios de cultura Himedia, você está fazendo um investimento inteligente que não apenas melhora a qualidade de suas pesquisas, mas também é amigável ao seu orçamento.
Conclusão
Em resumo, os meios de cultura Himedia são uma escolha inteligente para qualquer laboratório que busca qualidade, confiabilidade e variedade em seus produtos. Ao fazer essa escolha, você está agregando valor ao seu laboratório, garantindo resultados precisos e contribuindo para o avanço da pesquisa científica. Com a Himedia, você pode confiar na qualidade, pureza e consistência de seus meios de cultura, tornando-os uma escolha que vale a pena repetir em seu laboratório. Portanto, considere a Himedia como parceira em suas pesquisas e experimentações, e experimente os benefícios que seus produtos podem oferecer ao seu trabalho científico.
Precisando de meios de Cultura Himedia, entre em contato conosco.
AVISO DE DIREITOS AUTORAIS: Todo o material deste blog, sendo proibida toda e qualquer forma de plágio, cópia, reprodução ou qualquer outra forma de uso.
Qualquer dúvida técnica sobre os equipamentos contidos no portfólio SPLABOR, entre em contato com o Departamento de Vendas (sp@splabor.com.br)

A Splabor é uma empresa líder no ramo de fabricação de equipamentos para laboratório, especializada em oferecer uma ampla variedade de equipamentos para laboratórios, materiais e produtos para laboratório de alta qualidade.